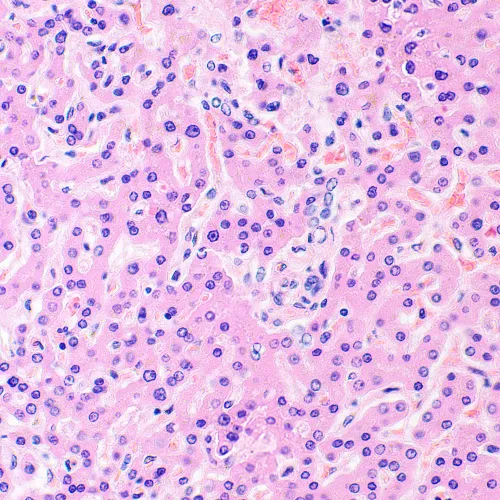
foto MAGUS Bio 290T Biyoloji Mikroskobu,  28

MAGUS Bio 290T Biyoloji Mikroskobu
Büyütme: 40–1000x. Ayarlanabilir eğim açısına sahip trinoküler başlık, motorlu döner burun parçası ve kondansatör, plan akromatik objektifler, 3 W LED aydınlatıcı, akıllı aydınlatma kontrol sistemi
| Ürün kimliği | 83482 |
| Marka | MAGUS |
| Garanti | 5 yıl |
| EAN | 5905555019482 |
| Paket boyutu (UxGxY) | 78x56x57 cm |
| Nakliye Ağırlığı | 21 kg |
Araştırma sınıfı mikroskop. Aydınlık alan yöntemini kullanarak geçirimli ışıkta yaymalar ve kesitler gibi saydam ve yarı saydam biyolojik örnekleri gözlemlemek için tasarlanmıştır. Ek aksesuarların takılması, karanlık alan, faz kontrast, diferansiyel girişim kontrastı, floresan ve polarizasyon yöntemlerine olanak sağlar.
Motorlu döner burun parçası ve kondansatör, hedeflerin değiştirilmesi ve her biri için aydınlatma sisteminin ayarlanması sürecini otomatik hale getirir. Kullanıcının ayarlar nedeniyle dikkati dağılmaz ve bu nedenle dikkati eldeki araştırmaya odaklanır ve bu da aktiviteyi hızlandırır.
Mikroskop, mikrobiyolojik analiz, tıbbi teşhis ve bilimsel ve araştırma problemlerinin çözümü için uygundur.
Mikroskop başlığı
Sonsuz düzeltilmiş optik parçalı trinoküler başlık. Kullanıcı, mikroskop kafasının 0° ila 35° aralığında en rahat eğim açısını seçer. Dijital kamera, trinoküler tüpe monte edilmiştir. Işın 0/100, 100/0 veya 80/20 oranında bölünür.
Temel kit, diyoptri ayarlı 10x/25 mm göz merceklerine ve gözlüklerle çalışmak için uzun bir göz mesafesine sahiptir.
Döner burun parçası ve objektifler
6 objektif için motorlu döner burun parçası iç kısma doğru yönlendirilmiştir: Kullanıcı optik yola yerleştirilmiş objektifi görür ve nesne tablasının üzerindeki alan boştur. Ekstra büyütme elde etmek için boş yuvaya ek bir objektif de takılabilir. Objektifler plan akromatiktir, parfokal yüksekliği – 60 mm.
Burun parçasının üstünde bir analizör, kompansatör veya diferansiyel girişim kontrast kaydırıcılarını takmak için fişli bir yuva bulunur.
Döner burun parçasının uzaktan kumandası
Mikroskobun ön panelinde objektif seçim düğmeleri bulunur. Döner burun parçası, bir düğmeye basıldığında seçilen objektifi otomatik olarak çalışma konumuna ayarlar. En sık kullanılan iki hedef arasında geçiş yapmak için ayrı bir düğme kullanılır.
Gövdenin her iki yanında odaklama düğmelerinin yanında burun parçasını döndürmeye yarayan düğmeler bulunur.
Aydınlatma ve kondansatör konumu, seçilen hedefe uyacak şekilde otomatik olarak ayarlanır.
Bu özellikler kullanıcı konforunu, hızını ve verimliliğini artırır. Her numune için çekim koşulları aynı kaldığı için mikrofotoğrafçılığa avantaj sağlarlar.
Büyütme oranları arasında geçiş yaparken konforlu parlaklık seviyelerinin korunması
Farklı büyütme oranlarındaki objektifler, ışığı farklı yoğunluk düzeylerinde iletir, bu nedenle, objektifleri her değiştirdiğinizde ışığın parlaklığının ayarlanması gerekir. Ayrıca, daha yüksek büyütme oranına sahip bir objektiften daha düşük büyütme oranına sahip bir objektife geçiş yapıldığında parlaklık keskin bir şekilde artar. Keskin bir parlaklık artışı göz yorgunluğuna neden olur. MAGUS Bio 290T akıllı parlaklık kontrolü ile donatılmıştır. Mikroskop, kullanıcının seçtiği her objektifin parlaklığını hatırlar ve burun parçasını çevirirken parlaklığı otomatik olarak ayarlar. Akıllı kontrol, parlaklığı ayarlamak için gereken süreyi azaltır. MAGUS Bio 290T kullanıcı konforunu arttırır ve sık sık büyütme değişimi gerektiren işlerde bile zaman tasarrufu sağlar.
Odaklama mekanizması
Kaba ve ince odaklama düğmeleri aynı eksen üzerinde ve alçakta konumlandırılmıştır. Araştırmacı ellerini masaya koyabilir ve mikroskobun önünde rahat bir poz alabilir.
Kaba odak kilitleme düğmesi, çalışma nesnesini değiştirdikten sonra mikroskobu hızlı bir şekilde ayarlamanıza yardımcı olur. Düğme, mikroskobun sol tarafında, odaklama mekanizmasıyla aynı eksende bulunur.
Sağ taraftaki halka kaba odaklama hareketinin gerginliğini ayarlar. Kullanıcı, iş için konforlu olan gerginliği ayarlar.
Nesne Tablası
Nesne tablası safir camdan imal edilmiştir. Safir cam çizilmeye ve kimyasallara karşı direncin yanı sıra sertlik ve dayanıklıkta elmas camdan sonra ikinci sıradadır. Popüler kimyasal tempereli Gorilla Glass’tan oldukça üstündür. Mohs skalasına göre (mineral yüzeylerin göreli sertliğini gösteren on puanlık bir skala), Gorilla Glass’ın puanı 6,8, safirin puanı 9 ve elması 10’dur. Örnek tutucu iki vidayla sabitlenir ve manuel tarama sırasında kolayca çıkarılabilir. Uzun nesne tablası kontrol kolu çalışırken kullanıcı konforunu sağlar: Kullanıcının eli zorlanmadan masanın üzerinde durabilir.
Kondansatör
Her hedef için optimum kondansatör ayarları: Döner yardımcı mercek, düşük büyütmeli hedefler için otomatik olarak ışın yolunun dışına çıkar ve 10x'ten büyük büyütmeli hedefler için geri döner. Daha az manuel adım – hızlı ve rahat çalışma için. Kullanıcı ayrıca belirli çalışmalar için döner yardımcı kondansatör merceğin konumunu ayrı ayrı ayarlayabilir.
Kondansatörün yüksekliği ayarlanabilir ve merkezlenebilir. Montaj tipi: kırlangıç.
Kondansatör halkası iris açıklığı diyaframını ayarlar. Kondansatör gövdesinde objektif büyütme için beyaz açıklık işaretleri ve renkli işaretler bulunur ve halkada bir gösterge işareti bulunur. Her objektifte kontrast elde etmek için gösterge işaretleyicinin açıklık veya kullanılan objektifin büyütme işaretiyle eşleşeceği şekilde halkanın döndürülmesi önerilir.
Aydınlatma
Geçirimli ışık aydınlatıcıda 3 W LED bulunur. Parlaklığı ayarlarken renk sıcaklığı değişmez. LED'in ömrü 50.000 saattir.
Geçirimli ışıkta Köhler aydınlatması
Görüntü kontrastı, kondansatörün açıklık diyaframıyla ve aydınlatılan alan, toplayıcının alan diyaframıyla ayarlanır. Alan diyafram kontrolü, gövdenin alt kısmında sağda, odak ayarlama alanının yanında bulunur. Bu, Köhler aydınlatma kurulumunu basitleştirir.
Köhler aydınlatma, gözlemlenen örneğin görüntü kalitesini artırır: Her objektif maksimum çözünürlüğe ulaşır ve görüş alanı kenarlarda kararma olmadan eşit şekilde aydınlatılır. İncelenen nesneye keskin bir şekilde odaklanılır ve görüntüdeki yapaylıklar ortadan kaldırılır.
Ergonomik tasarım
Fiziksel rahatsızlık yorgunluğa neden olur ve üretkenliği azaltır. Mikroskobun ergonomik tasarımı günlük bilimsel araştırmalarda önemli bir rol oynar.
MAGUS Bio 290T çalışma sırasında kullanıcı konforu sağlar.
Motorlu bileşenler, hedefleri sık sık değiştirirken hızı artırır ve tekrarlanan görevleri basitleştirir.
Kullanıcı, sırt ve boynun yorulmaması için rahat bir mikroskop başlığı eğim açısını seçer.
Odaklama düğmeleri gövdenin en altında bulunur. Kullanıcının ellerini zorlaması gerekmez. Mekanizmanın yumuşak hareketi sayesinde kullanıcı zahmetsizce nesneye odaklanabilir.
Uzun nesne tablası kontrol kolu ve hassas odaklama düğmesi aynı çalışma alanında bulunduğu için mikroskop minimum el hareketi ile kullanılır.
Aksesuarlar
Bu mikroskop için tasarlanmış bir aksesuar serisi bulunmaktadır.
İsteğe bağlı objektifler ek büyütme sağlar.
Göz mercekleri mikroskobun büyütme aralığını genişletir. İsteğe bağlı göz mercekleri, en sık kullandığınız objektifin potansiyelini maksimuma çıkarmanıza yardımcı olur.
Faz kontrast cihazları, floresan eklentisi, karanlık alan yoğunlaştırıcıları, polarizasyon cihazları ve DIC cihazları kontrast yöntemlerini genişletir ve aydınlık alanda görünmeyen nesnelerin incelenmesine olanak tanır.
Bir dijital kamera, mikroskop görüntüsünü bir monitöre aktarıp dosyaları saklar ve yazılım ise örneklerin gerçek zamanlı ölçümlerini alır.
Kalibrasyon lamı, nesneleri ölçmek için kullanılır ve ölçekli bir göz merceği veya kamera yazılımıyla birlikte kullanılabilir.
Önemli özellikler:
- Geçirimli ışıkta aydınlık alanda şeffaf ve yarı saydam örneklerin gözlemlenmesi
- Dijital kamera takmak ve eğim açısını değiştirmek için dikey tüplü trinoküler başlık; 0/100, 100/0 veya 80/20 ışın demeti ayırma
- Motorlu döner burun parçası – çalışma hedeflerinin değiştirilmesi bir düğmeye basılarak gerçekleşir; döner parçanın uzaktan kontrolü için kullanışlı panel
- Geçirimli ışık aydınlatıcı, 50.000 saate kadar kullanım ömrüne sahip enerji tasarruflu 3 W LED’dir
- Geçirimli ışık Köhler aydınlatması, dönebilen yardımcı mercekli motorlu kondansatör
- Akıllı aydınlatma kontrol sistemi – çalışma hedefi değiştirilirken otomatik parlaklık seçimi
- Nesne tablası bir safir cam tablaya sahiptir, kullanım sırasında rahatlık için uzun bir kontrol koluna sahiptir
- Geniş uyumlu isteğe bağlı aksesuar yelpazesi
Kit içeriği:
- Yerleşik güç kaynağı, odaklama mekanizması, nesne tablası, kondansatör kundağı ve motorlu döner burunluk içeren stand
- Lamba yuvalı geçirimli ışık aydınlatıcı
- Dönebilen yardımcı mercekli motorlu döner kondansatör
- Trinoküler başlık
- Plan akromatik sonsuzluk düzeltmeli objektif: 4x/0,10, parfokal yüksekliği 60 mm
- Plan akromatik sonsuzluk düzeltmeli objektif: 10x/0,25, parfokal yüksekliği 60 mm
- Plan akromatik sonsuzluk düzeltmeli objektif: 20x/0,40, parfokal yüksekliği 60 mm
- Plan akromatik sonsuzluk düzeltmeli objektif: 40x/0,65 (yaylı), parfokal yüksekliği 60 mm
- Plan akromatik sonsuzluk düzeltmeli objektif: 100x/1,25 yağ (yaylı), parfokal yüksekliği 60 mm
- Uzun göz mesafeli ve diyoptri ayarlı 10x/25 mm göz merceği (2 adet)
- Göz merceği vizörü (2 adet)
- Işık filtresi
- C-mount kamera adaptörü
- AC güç kablosu
- Toz kapağı
- Kullanım kılavuzu ve garanti kartı
Talep üzerine mevcuttur:
- Ölçekli 10x/22 mm göz merceği
- Artıkıllı 10x/22 mm göz merceği
- Artı işaretli 10x/22 mm göz merceği
- 12,5x/17,5 mm göz merceği (2 adet)
- 15x/16 mm göz merceği (2 adet)
- 20x/12 mm göz merceği (2 adet)
- Faz kontrast cihazı: faz kontrast kondansatörü, yardımcı merkezleme teleskobu, faz objektif seti
- Karanlık alan kondansatörü NA 0,7–0,9
- Karanlık alan daldırma kondansatörü NA 1,3–1,26
- Diferansiyel girişim kontrastı (DIC) yöntemiyle çalışacak şekilde tasarlanmış cihaz
- Yansıtmalı ışık aydınlatıcı
- Polarizasyon cihazı
- Dijital kamera
- Kalibrasyon lamı
- Monitör
| Ürün kimliği | 83482 |
| Marka | MAGUS |
| Garanti | 5 yıl |
| EAN | 5905555019482 |
| Paket boyutu (UxGxY) | 78x56x57 cm |
| Nakliye Ağırlığı | 21 kg |
| Tip | biyolojik, ışık/optik |
| Mikroskop başlığı türü | üç gözlü |
| Başlık | ışın bölme 0/100, 100/0, 80/20 |
| Kafa eğim açısı | 0–35°, ayarlanabilir |
| Büyütme, x | 40 — 1000 |
| Büyütme, x (isteğe bağlı) | 40–1250/1500/2000 |
| 1 | |
| Göz merceği boru çapı, mm | 30 |
| Göz mercekleri | ±5D diyopter ayarlı 10x/25, uzun göz mesafesi (*isteğe bağlı: ölçekli 10x/22, retiküllü 10x/22, artı göstergeli 10x/22, 12,5x/17,5, 15x/16, 20x/12) |
| Objektifler | sonsuz plan akromatik: 4x/0,10; 10x/0,25; 20х/0,40; 40xs/0,65; 100xs/1,25 yağ; parfokal mesafe: 60 mm |
| Döner burun parçası | 6 objektif, motorlu |
| Lamel yuvası, mm | 190x152 |
| Lamel yuvası hareket aralığı, mm | 78/32 |
| Lamel yuvası özellikleri | iki eksenli mekanik, safir cam tablalı |
| Göz merceği diyopter ayarı, diyopterler | her bir göz merceğinde ±5D |
| Göz merceği diyopter ayarı | ✓ |
| Kondansatör | dönebilen ön lensli motorlu döner kondansatör NA 0,9/0,25; ortalanmış ve yüksekliği ayarlanabilir, ayarlanabilir açıklık diyaframına sahip; kırlangıç kuyruğu kundak |
| Diyafram | ayarlanabilir açıklık diyaframı, ayarlanabilir iris alanı diyaframı |
| Odak | koaksiyel, kaba (35 mm, 18,85 mm/daire, kilit düğmeli ve gerilim ayar düğmeli) ve ince (0,001 mm) |
| Aydınlatma | LED |
| Parlaklık ayarı | ✓ |
| Güç kaynağı | 100–240 V, 50/60 Hz, AC ağı |
| Işık kaynağı türü | 3 W LED |
| Işık filtreleri | evet |
| Çalışma sıcaklığı aralığı, °C | 5...+40 |
| Ek | objektif değiştirirken otomatik parlaklık ayarı |
| Ek cihaz bağlama özelliği | diferansiyel girişim kontrastı (DIC) yöntemiyle çalışacak şekilde tasarlanmış cihaz , faz kontrast cihazı (kondansatör ve objektifler), karanlık alan kondansatörü (kuru veya yağ), polarizasyon cihazları (polarizör ve analizör), yansıtmalı ışık aydınlatıcı |
| Kullanıcı seviyesi | deneyimli kullanıcılar, profesyoneller |
| Montaj ve kurulum zorluk seviyesi | karmaşık |
| Uygulama | laboratuvar/tıbbi |
| Aydınlatma konumu | daha düşük |
| Araştırma yöntemi | parlak alan |
| Kese/çanta/torba sete dahildir | toz kapağı |